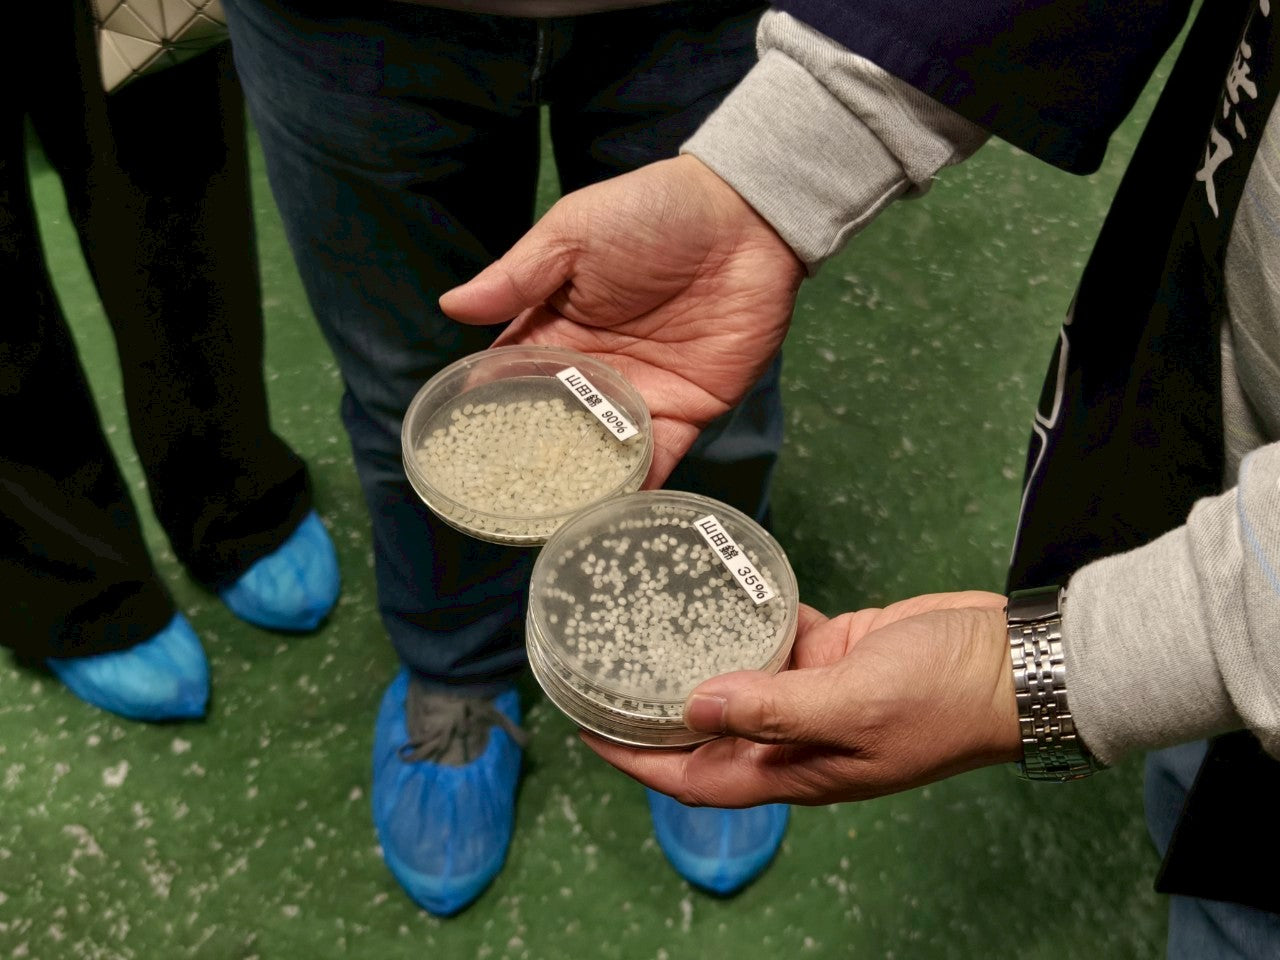
北海道清酒愛好者之旅|酒藏探訪 × 職人釀造 × 美食配酒五日行

小林酒造(栗山)|北の錦
北海道最古老酒藏群 × 明治木造老藏 × 老街與「小林家」古宅相連
- 喝前要懂:石狩平原稻作+寒涼長發酵,骨架俐落、乾淨收尾。
- 現場看點:從洗米、製麴到壓榨,完整動線一覽無遺;史料室映照百年商號的野心。小林酒造的發展史是北海道開拓史的縮影,若由家主親述,更像在聽一首以釀酒為音符的家族興衰樂章。
- 必喝線索:以「爽口 → 吟釀 → 旨口」階梯品飲,抓住吟釀香與米旨的平衡點。













你不只是喝酒,你在讀風土。|三大百年酒藏 × 小樽清酒屋形船 × 法式清酒搭餐
把「北緯」與「酒度」一起喝懂——從石狩平原到日本海港町,再到內陸嚴寒之都,用五天把北海道的清酒脈絡一次梳順。
北海道最古老酒藏群 × 明治木造老藏 × 老街與「小林家」古宅相連
日本最北端酒藏 × 港町與鰊漁文化 × 海霧與寒流的辛口底色
內陸嚴寒 × 大礦坑時代 × 低溫長期發酵的天然試驗場
| 行程名稱 | 北海道清酒行家的選擇|三大酒藏 × 屋形船 × 法式清酒搭餐(5日) |
|---|---|
| 出發日期 | 彈性出發;釀造期參觀名額有限,建議提前預約(4–10 月) |
| 適合對象 | 清酒愛好者、餐酒搭配愛好者、想把「風土」喝懂的你 |
| 成團規模 | 8–16 人最佳(可特殊客製) |
| 包含 | 專車與司機、中文嚮導/領隊、三大酒造導覽+基本品飲、茶道體驗、壽司 DIY、清酒屋形船(或室內 pairing 備案)、四晚住宿(雙人一室)等 |
| 不含 | 國際/國內機票、未列餐食、個人消費、加點高階酒款、單人房差、小費、保險 |
| 飲酒安全 | 20 歲以上始得飲酒;全程禁酒駕;孕婦或對酒精敏感者請事前告知 |
告知人數|預算|偏好風格,可提供初版動線與報價區間。
想延伸威士忌/咖啡烘焙/職人藍染?留言,我們把五天升級成六天。
選擇選項